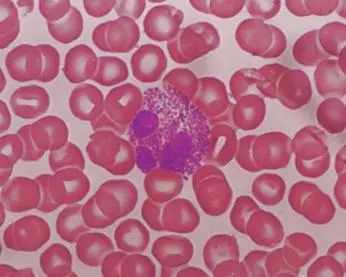

嗜酸粒细胞对肠道菌群的适应性起着重要的调控作用
《Immunity》 上的一项新研究中发现,嗜酸性粒细胞在促进宿主和肠道微生物组(肠道菌群)之间共生相互作用方面扮演了极为关键的角色。这一发现使人们对 嗜酸性粒细胞的作用产生了新的认识。这一发现将会激发对这些相对稀有细胞的更深入研究,从而为嗜酸性粒细胞相关疾病的干预措施提供新的治疗靶点。
嗜酸性粒细胞
人体粒细胞包括中性粒细胞、嗜酸性粒细胞和嗜碱性粒细胞。其中嗜酸性粒细胞是人体白细胞的组成成分,来源于骨髓的造血干细胞。嗜酸性粒细胞 属于多功能粒细胞,它既是免疫反应期间极为重要的效应细胞,具有杀伤细菌、寄生虫的功能;同时也参与过敏反应。在健康人群中,嗜酸性粒细胞约占白细胞的1-2%;但在严重过敏人群中,这一数字会显著增加。嗜酸性粒细胞还会释放引起组织损伤,促进炎症进展的物质。
早前科学家们发现最大的嗜酸性粒细胞群竟然会常驻在肠道中,占肠道白细胞的10%-30%,然而目前研究人员并不清楚肠道嗜酸性粒细胞(eosinophils)的功能。

早期对嗜酸性粒细胞的研究主要集中在其对蠕虫感染的反应或在过敏性疾病(包括哮喘和嗜酸性食管炎)的病理生理过程中的作用。最近的研究发现,嗜酸性粒细胞主要分布在胃肠道。在妊娠晚期和生命早期,它们就被募集到肠道,并且这一行为与肠道菌群无关。肠道嗜酸性粒细胞参与其他免疫细胞群的免疫调节和维持,尤其是在小肠内;但它们是否会影响小肠的正常生理功能仍是未知的。
这项研究结果揭示了嗜酸性粒细胞在促进宿主和微生物群落之间的相互作用方面发挥着关键角色,这或许能改变人们对嗜酸性粒细胞功能的看法。嗜酸性粒细胞在发达国家的健康人群机体循环的白细胞中占到了大约1%-2%的比例,同时其在严重过敏症的患者机体中的数量会增加,其在这些过敏反应发生过程中发挥着组织破坏性的病理性角色。

研究人员利用无菌动物模型和先进的3D显微镜技术分析了嗜酸性粒细胞在小肠主要功能中可能发挥的作用。结果发现,嗜酸性粒细胞或许能协调肠道对细菌的反应。
虽然嗜酸性粒细胞的募集不需要肠道菌群,但微生物定植导致了嗜酸性粒细胞的更新和活化。 研究人员还发现嗜酸性粒细胞协调肠道对细菌的反应。它们限制了炎症,从而进一步限制了组织损伤。造成这种损伤的最重要因素是小肠绒毛。
目前研究人员正在限制患者机体过度的炎症表现,而通过这样做就能限制组织的损伤,这种损伤最重要的因素就是绒毛的长度,即肠道壁上存在的手指状的突起,其能帮助吸收营养物质;研究者发现,嗜酸性粒细胞能保持这些绒毛的完整性,而没有这些细胞,绒毛就会变得更短,同时脂质的吸收也会减少。因此,嗜酸性粒细胞能够帮助维持这个吸收区域,从而使得从饮食中获得的营养物质达到适当的水平。研究人员还发现,在没有嗜酸性粒细胞存在的情况下,肠道的运动会失调,这或许就会影响组织的结构。

了解微生物或炎症驱动的不同嗜酸性粒细胞亚群激活的机制,这些可以帮助深入了解肠道稳态与疾病的驱动因素,并可能为嗜酸性粒细胞相关疾病的干预提供新的治疗靶点。

关注恒泰善行公众号,获取每日健康资讯

